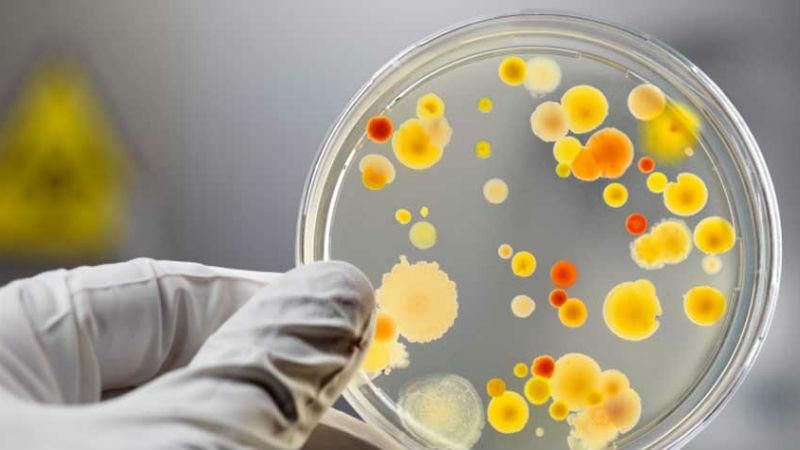
Ще один випадок ботулізму зафіксували у Києві Ще один випадок ботулізму зафіксували у Києві

Про це повідомили у Держпродспоживслужбі, пише УНІАН.
Чоловік відчув погіршення через два дні після вживання риби і відразу звернувся до медиків. Лікарі встановили попередній діагноз "ботулізм".
Його госпіталізували в реанімаційне відділення.
Медики настійно просять громадян утриматися від вживання в'яленої риби виробництва ФОП Меркулов А.В.
Нагадаємо, 30 травня у Києві в'ялена риба, куплена у супермаркеті, стала причиною смерті 40-річного киянина. Ще троє – госпіталізовані у тяжкому стані з діагнозом ботулізм.